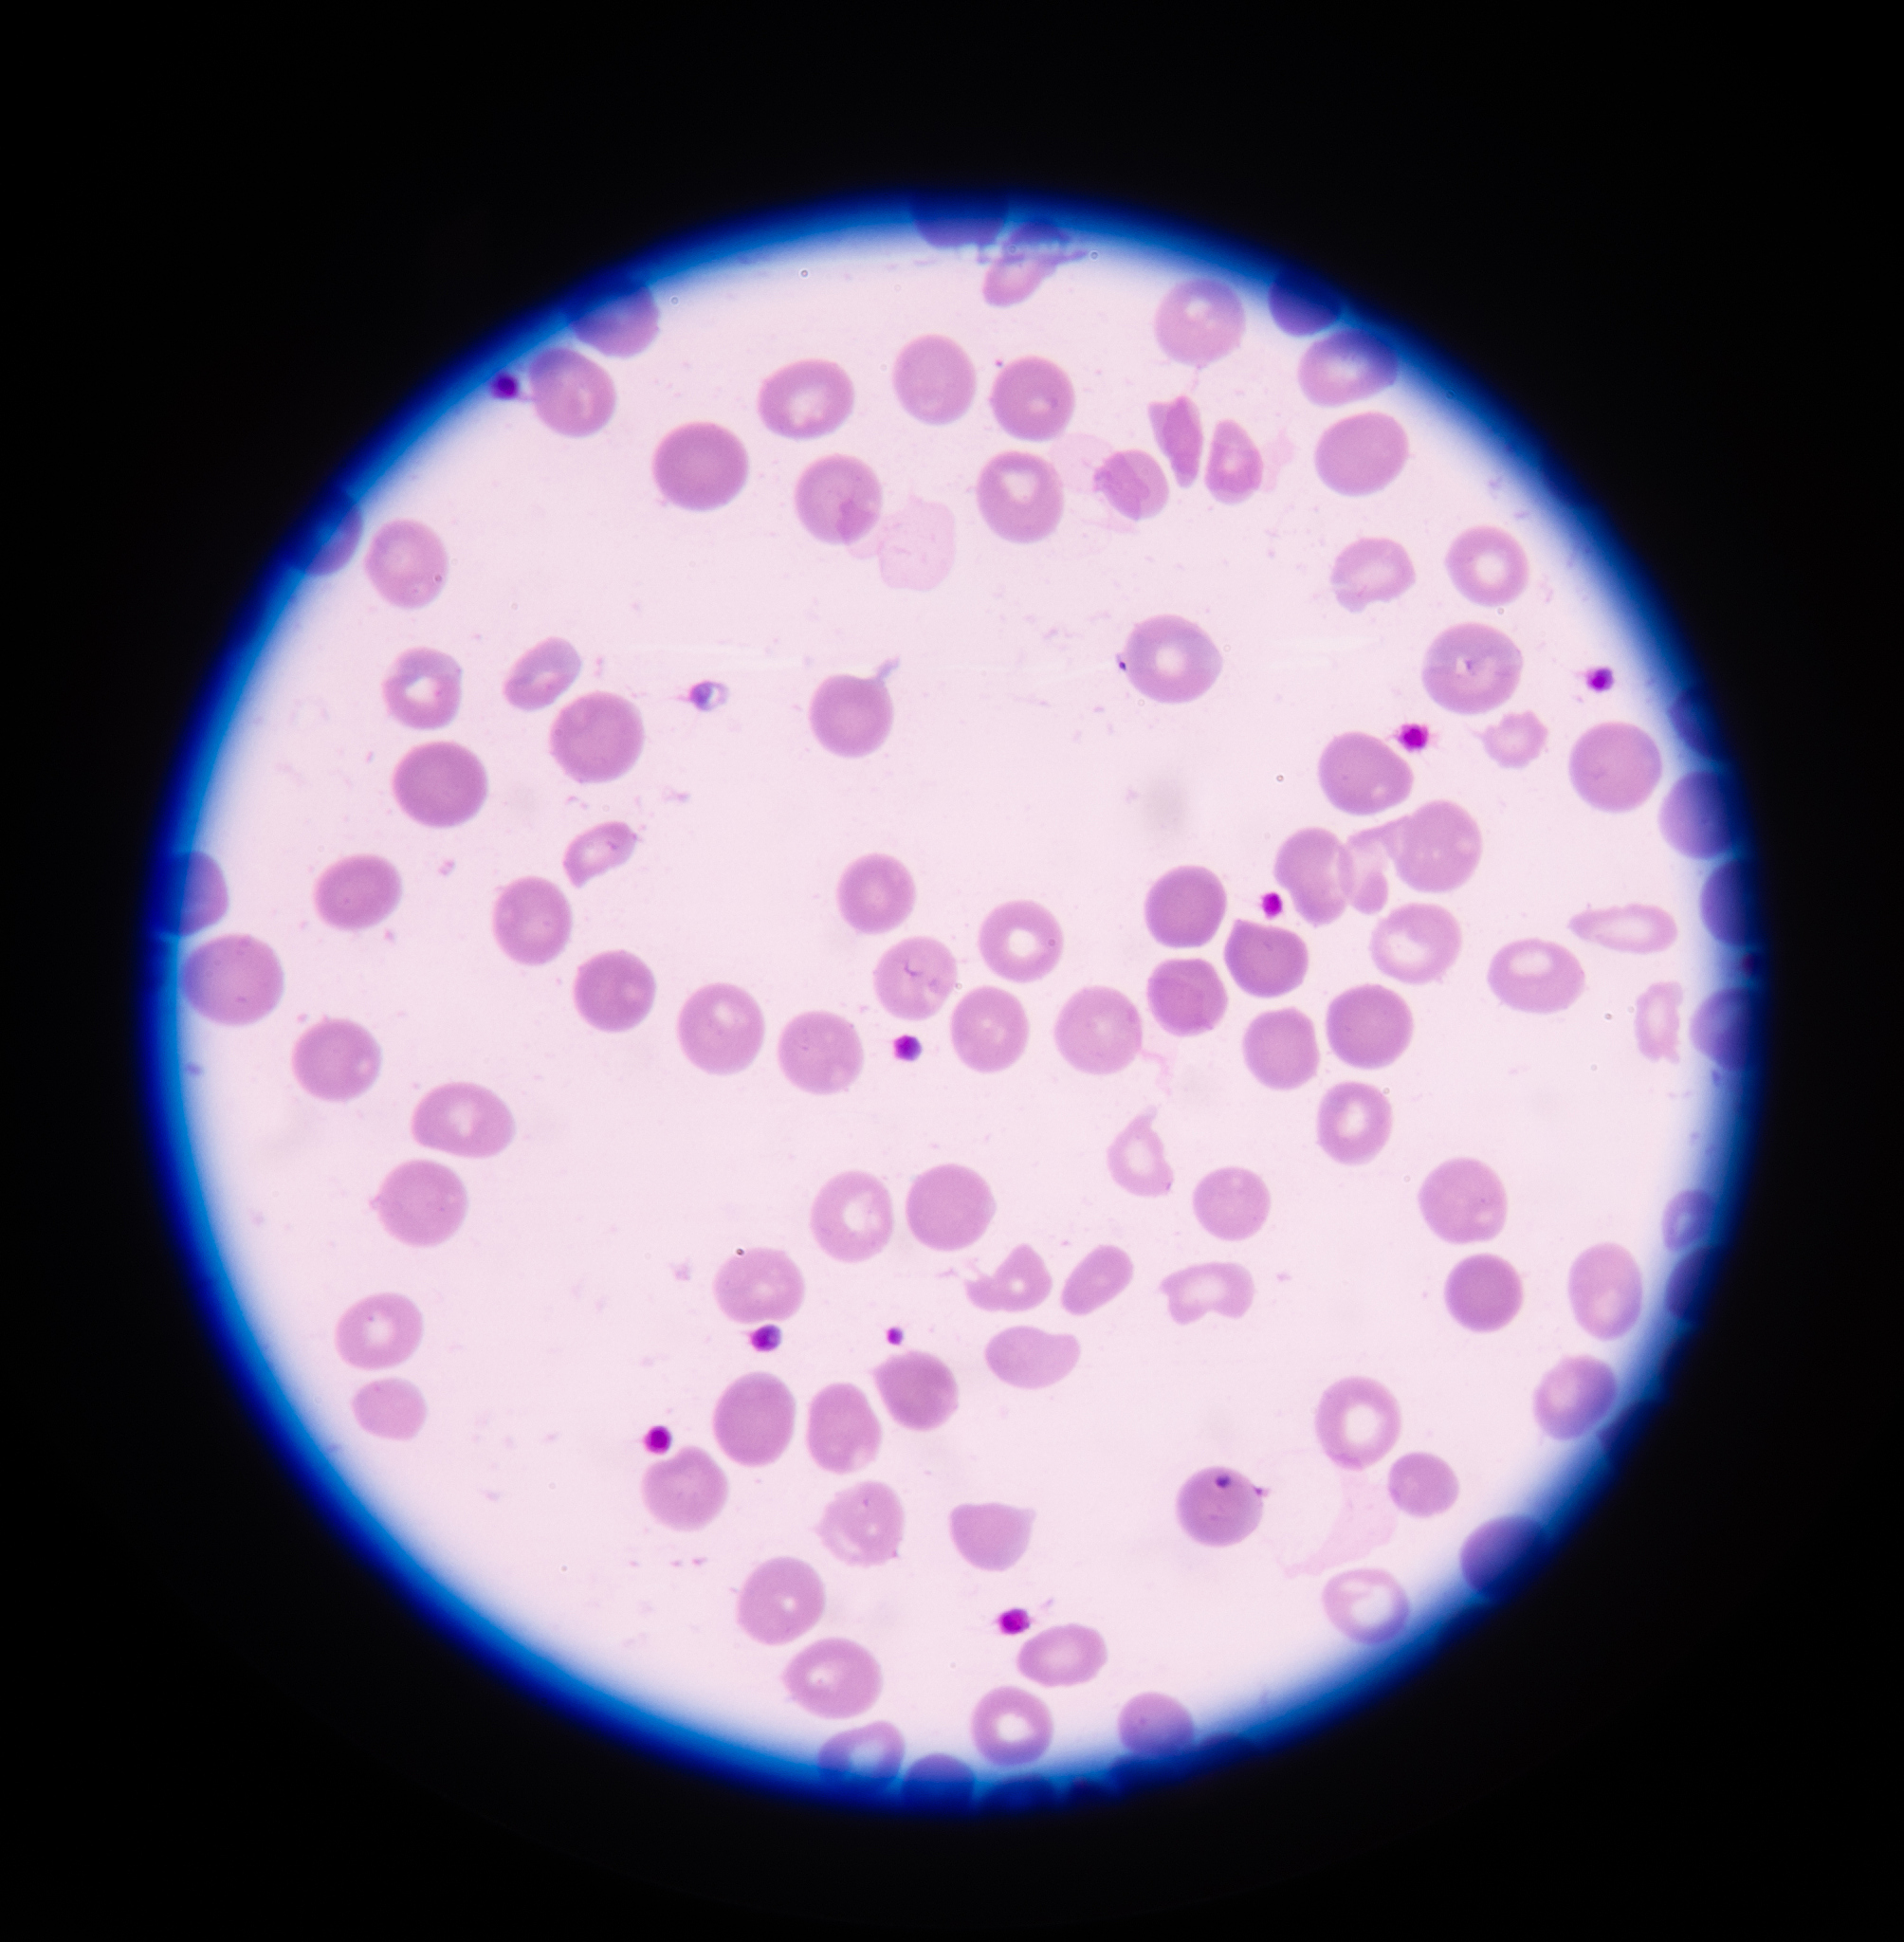
哌拉西林会引起骨髓造血停滞吗

哌拉西林会引起骨髓造血停滞吗
哌拉西林可能会引起骨髓造血停滞,但这种情况比较罕见。哌拉西林属于青霉素类抗生素,可能会对造血系统产生一定的影响,导致骨髓细胞生成减少,从而引起贫血、白细胞减少等症状。如果出现这种情况,应立即就医。

原文地址: https://www.cveoy.top/t/topic/cx89 著作权归作者所有。请勿转载和采集!
安全问答是一个知识全球问答,包含丰富的问答知识
哌拉西林可能会引起骨髓造血停滞,但这种情况比较罕见。哌拉西林属于青霉素类抗生素,可能会对造血系统产生一定的影响,导致骨髓细胞生成减少,从而引起贫血、白细胞减少等症状。如果出现这种情况,应立即就医。
原文地址: https://www.cveoy.top/t/topic/cx89 著作权归作者所有。请勿转载和采集!